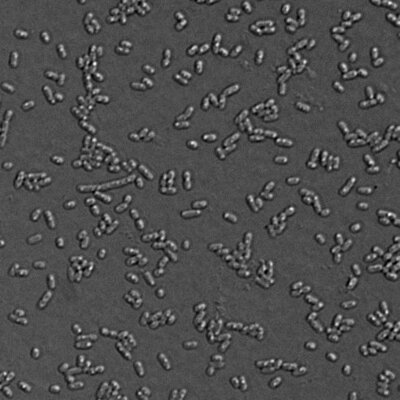
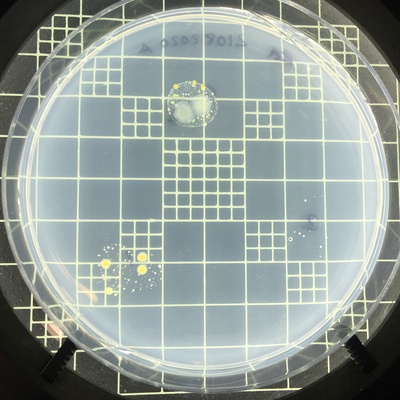

Recent photos
-

inconnu, 10 October 2021 -

inconnu, 9 October 2021 -

Municipal parc, 13 July 2022 -

Lac du Marcheur, 13 July 2022 -

Camping Lac Copping, 13 July 2022 -

Chez Gilles , 13 July 2022 -

Lac Brodeur, 14 July 2022 -

Chez Jocelyne, 14 July 2022 -

Chez Susan, 14 July 2022 -

Chez Jacques, 14 July 2022 -
Lachine Canal at Pont Charlevoix, 21 August 2020 -

Lachine Canal at Pont Charlevoix, 21 August 2020 -
Lachine Canal at Pont Charlevoix, 21 August 2020 -

Lachine Canal at Pont Charlevoix, 21 August 2020 -

Parc Jarry, Montreal, 29 May 2022 -

Parc Jarry, Montreal, 29 May 2022 -
Lac Parent, 7 May 2022 -
Source d'eau, 7 May 2022 -

Source d'eau, 7 May 2022 -
Parc Jarry, Montreal, 6 May 2022